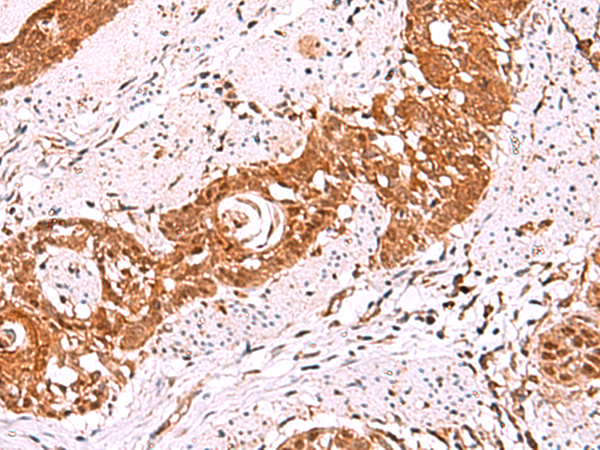

宿 主: Rabbit
技術(shù)規(guī)格
Background:
This gene encodes a member of the iroquois homeobox gene family, which are involved in several embryonic developmental processes. Knockout mice lacking this gene show that it is required for retinal cone bipolar cell differentiation, and that it negatively regulates potassium channel gene expression in the heart to ensure coordinated cardiac repolarization. Alternatively spliced transcript variants encoding different isoforms have been found for this gene.
Applications:
ELISA, WB, IHC
Name of antibody:
IRX5
Immunogen:
Synthetic peptide of human IRX5
Full name:
iroquois homeobox 5
Synonyms:
HMMS; IRXB2; IRX-2a
SwissProt:
P78411
ELISA Recommended dilution:
5000-10000
IHC positive control:
Human lung cancer and Human esophagus cancer
IHC Recommend dilution:
30-150
WB Predicted band size:
50 kDa
WB Positive control:
Mouse lung tissue lysate
WB Recommended dilution:
200-1000

購(gòu)物車
幫助
021-54845833/15800441009
